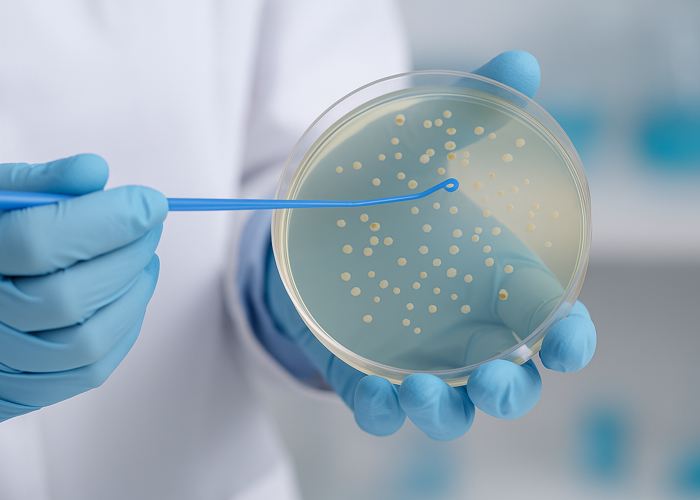
Бактериологический посев мочи

–Ч–∞—П–≤–Ї–∞ –њ—А–Є–љ—П—В–∞

–Я—А–Є—З–Є–љ—Л –Є –Љ–µ—Е–∞–љ–Є–Ј–Љ—Л —А–∞–Ј–≤–Є—В–Є—П —Г—А–µ—В—А–Њ—Ж–Є—Б—В–Є—В–∞
–£—А–µ—В—А–Њ—Ж–Є—Б—В–Є—В вАФ –≤–Њ—Б–њ–∞–ї–Є—В–µ–ї—М–љ–Њ–µ –Ј–∞–±–Њ–ї–µ–≤–∞–љ–Є–µ, –њ–Њ—А–∞–ґ–∞—О—Й–µ–µ –Њ–і–љ–Њ–≤—А–µ–Љ–µ–љ–љ–Њ —Г—А–µ—В—А—Г –Є —Б–ї–Є–Ј–Є—Б—В—Г—О –Њ–±–Њ–ї–Њ—З–Ї—Г –Љ–Њ—З–µ–≤–Њ–≥–Њ –њ—Г–Ј—Л—А—П. –І–∞—Й–µ –≤—Б–µ–≥–Њ –Њ–љ–Њ —А–∞–Ј–≤–Є–≤–∞–µ—В—Б—П –љ–∞ —Д–Њ–љ–µ –±–∞–Ї—В–µ—А–Є–∞–ї—М–љ–Њ–є –Є–љ—Д–µ–Ї—Ж–Є–Є, –Ї–Њ—В–Њ—А–∞—П –њ—А–Њ–љ–Є–Ї–∞–µ—В –≤–Њ—Б—Е–Њ–і—П—Й–Є–Љ –њ—Г—В—С–Љ –Є–Ј —Г—А–µ—В—А—Л –≤ –Љ–Њ—З–µ–≤–Њ–є –њ—Г–Ј—Л—А—М. –Т–Њ–Ј–±—Г–і–Є—В–µ–ї—П–Љ–Є –Љ–Њ–≥—Г—В –±—Л—В—М –Ї–Є—И–µ—З–љ–∞—П –њ–∞–ї–Њ—З–Ї–∞, —Б—В–∞—Д–Є–ї–Њ–Ї–Њ–Ї–Ї–Є, —Е–ї–∞–Љ–Є–і–Є–Є –Є–ї–Є –Љ–Є–Ї–Њ–њ–ї–∞–Ј–Љ—Л. –Ґ–∞–Ї–ґ–µ –Ј–∞–±–Њ–ї–µ–≤–∞–љ–Є–µ –Љ–Њ–ґ–µ—В —А–∞–Ј–≤–Є—В—М—Б—П –њ–Њ—Б–ї–µ –њ–µ—А–µ–Њ—Е–ї–∞–ґ–і–µ–љ–Є—П, —В—А–∞–≤–Љ –Є–ї–Є –њ—А–Є –љ–∞—А—Г—И–µ–љ–Є–Є –Є–љ—В–Є–Љ–љ–Њ–є –≥–Є–≥–Є–µ–љ—Л.
–Ъ —Д–∞–Ї—В–Њ—А–∞–Љ, –њ—А–µ–і—А–∞—Б–њ–Њ–ї–∞–≥–∞—О—Й–Є–Љ –Ї —А–∞–Ј–≤–Є—В–Є—О —Г—А–µ—В—А–Њ—Ж–Є—Б—В–Є—В–∞, –Њ—В–љ–Њ—Б—П—В—Б—П:
- —Е—А–Њ–љ–Є—З–µ—Б–Ї–Є–µ –Є–љ—Д–µ–Ї—Ж–Є–Є –Љ–Њ—З–µ–њ–Њ–ї–Њ–≤–Њ–є —Б–Є—Б—В–µ–Љ—Л;
- —Б–љ–Є–ґ–µ–љ–Є–µ –Є–Љ–Љ—Г–љ–Є—В–µ—В–∞;
- –≥–Њ—А–Љ–Њ–љ–∞–ї—М–љ—Л–µ –љ–∞—А—Г—И–µ–љ–Є—П;
- –Ј–∞—Б—В–Њ–є –Љ–Њ—З–Є –Є–ї–Є –Ї–∞–Љ–љ–Є –≤ –Љ–Њ—З–µ–≤–Њ–Љ –њ—Г–Ј—Л—А–µ.
–Т–Њ—Б–њ–∞–ї–Є—В–µ–ї—М–љ—Л–є –њ—А–Њ—Ж–µ—Б—Б –≤—Л–Ј—Л–≤–∞–µ—В –Њ—В—С–Ї —Б–ї–Є–Ј–Є—Б—В–Њ–є, –±–Њ–ї–Є, –ґ–ґ–µ–љ–Є–µ –њ—А–Є –Љ–Њ—З–µ–Є—Б–њ—Г—Б–Ї–∞–љ–Є–Є –Є —З–∞—Б—В—Л–µ –њ–Њ–Ј—Л–≤—Л. –Я—А–Є –Њ—В—Б—Г—В—Б—В–≤–Є–Є –ї–µ—З–µ–љ–Є—П –≤–Њ—Б–њ–∞–ї–µ–љ–Є–µ –Љ–Њ–ґ–µ—В –њ–µ—А–µ–є—В–Є –≤ —Е—А–Њ–љ–Є—З–µ—Б–Ї—Г—О —Д–Њ—А–Љ—Г –Є –≤—Л–Ј—Л–≤–∞—В—М –Њ—Б–ї–Њ–ґ–љ–µ–љ–Є—П, –≤–Ї–ї—О—З–∞—П –њ–Њ—А–∞–ґ–µ–љ–Є–µ –њ–Њ—З–µ–Ї. –Я–Њ—Н—В–Њ–Љ—Г —А–∞–љ–љ—П—П –і–Є–∞–≥–љ–Њ—Б—В–Є–Ї–∞ –Є –њ—А–∞–≤–Є–ї—М–љ–∞—П —В–µ—А–∞–њ–Є—П –Є–Љ–µ—О—В –Ї–ї—О—З–µ–≤–Њ–µ –Ј–љ–∞—З–µ–љ–Є–µ –і–ї—П –њ—А–µ–і–Њ—В–≤—А–∞—Й–µ–љ–Є—П –Њ—Б–ї–Њ–ґ–љ–µ–љ–Є–є.
–Ъ–Њ–Љ–њ–ї–µ–Ї—Б–љ–Њ–µ –ї–µ—З–µ–љ–Є–µ –љ–∞–њ—А–∞–≤–ї–µ–љ–Њ –љ–∞ —Г—Б—В—А–∞–љ–µ–љ–Є–µ –Є–љ—Д–µ–Ї—Ж–Є–Є, —Б–љ—П—В–Є–µ –≤–Њ—Б–њ–∞–ї–µ–љ–Є—П –Є –≤–Њ—Б—Б—В–∞–љ–Њ–≤–ї–µ–љ–Є–µ –љ–Њ—А–Љ–∞–ї—М–љ–Њ–є —Д—Г–љ–Ї—Ж–Є–Є –Љ–Њ—З–µ–≤—Л–≤–Њ–і—П—Й–Є—Е –њ—Г—В–µ–є.
–Ф–Є–∞–≥–љ–Њ—Б—В–Є–Ї–∞ —Г—А–µ—В—А–Њ—Ж–Є—Б—В–Є—В–∞
–Ф–ї—П –њ–Њ–і—В–≤–µ—А–ґ–і–µ–љ–Є—П –і–Є–∞–≥–љ–Њ–Ј–∞ –≤—А–∞—З –њ—А–Њ–≤–Њ–і–Є—В –Ї–Њ–Љ–њ–ї–µ–Ї—Б–љ–Њ–µ –Њ–±—Б–ї–µ–і–Њ–≤–∞–љ–Є–µ, –≤–Ї–ї—О—З–∞—О—Й–µ–µ –ї–∞–±–Њ—А–∞—В–Њ—А–љ—Л–µ –Є –Є–љ—Б—В—А—Г–Љ–µ–љ—В–∞–ї—М–љ—Л–µ –Љ–µ—В–Њ–і—Л. –Р–љ–∞–ї–Є–Ј—Л –Љ–Њ—З–Є –њ–Њ–Ј–≤–Њ–ї—П—О—В –≤—Л—П–≤–Є—В—М –љ–∞–ї–Є—З–Є–µ –≤–Њ—Б–њ–∞–ї–µ–љ–Є—П, –±–∞–Ї—В–µ—А–Є–є –Є –Ї–ї–µ—В–Њ—З–љ—Л—Е —Н–ї–µ–Љ–µ–љ—В–Њ–≤. –Я–Њ—Б–µ–≤ –Љ–Њ—З–Є –њ–Њ–Љ–Њ–≥–∞–µ—В –Њ–њ—А–µ–і–µ–ї–Є—В—М –≤–Њ–Ј–±—Г–і–Є—В–µ–ї—П –Є –µ–≥–Њ —З—Г–≤—Б—В–≤–Є—В–µ–ї—М–љ–Њ—Б—В—М –Ї –∞–љ—В–Є–±–Є–Њ—В–Є–Ї–∞–Љ, —З—В–Њ –≤–∞–ґ–љ–Њ –і–ї—П –њ–Њ–і–±–Њ—А–∞ —Н—Д—Д–µ–Ї—В–Є–≤–љ–Њ–є —В–µ—А–∞–њ–Є–Є.
–Ґ–∞–Ї–ґ–µ –Љ–Њ–≥—Г—В –њ—А–Є–Љ–µ–љ—П—В—М—Б—П:
- —Г—А–µ—В—А–Њ—Б–Ї–Њ–њ–Є—П –і–ї—П –≤–Є–Ј—Г–∞–ї—М–љ–Њ–є –Њ—Ж–µ–љ–Ї–Є —Б–Њ—Б—В–Њ—П–љ–Є—П —Б–ї–Є–Ј–Є—Б—В–Њ–є —Г—А–µ—В—А—Л;
- —Г–ї—М—В—А–∞–Ј–≤—Г–Ї–Њ–≤–Њ–µ –Є—Б—Б–ї–µ–і–Њ–≤–∞–љ–Є–µ –Љ–Њ—З–µ–≤–Њ–≥–Њ –њ—Г–Ј—Л—А—П;
- —Ж–Є—Б—В–Њ—Б–Ї–Њ–њ–Є—П –њ—А–Є –њ–Њ–і–Њ–Ј—А–µ–љ–Є–Є –љ–∞ —Е—А–Њ–љ–Є—З–µ—Б–Ї–Є–є –њ—А–Њ—Ж–µ—Б—Б.
–Ф–Є–∞–≥–љ–Њ—Б—В–Є–Ї–∞ –њ—А–Њ–≤–Њ–і–Є—В—Б—П –Є–љ–і–Є–≤–Є–і—Г–∞–ї—М–љ–Њ, —Б —Г—З—С—В–Њ–Љ –њ–Њ–ї–∞, –≤–Њ–Ј—А–∞—Б—В–∞ –Є –Њ—Б–Њ–±–µ–љ–љ–Њ—Б—В–µ–є –њ–∞—Ж–Є–µ–љ—В–∞. –Ц–µ–љ—Й–Є–љ–∞–Љ —З–∞—Б—В–Њ –љ–∞–Ј–љ–∞—З–∞—О—В –≥–Є–љ–µ–Ї–Њ–ї–Њ–≥–Є—З–µ—Б–Ї–Њ–µ –Њ–±—Б–ї–µ–і–Њ–≤–∞–љ–Є–µ, –∞ –Љ—Г–ґ—З–Є–љ–∞–Љ вАФ –Њ—Б–Љ–Њ—В—А —Г—А–Њ–ї–Њ–≥–∞ —Б –Њ—Ж–µ–љ–Ї–Њ–є —Б–Њ—Б—В–Њ—П–љ–Є—П –њ—А–µ–і—Б—В–∞—В–µ–ї—М–љ–Њ–є –ґ–µ–ї–µ–Ј—Л. –Ґ–∞–Ї–Њ–є –њ–Њ–і—Е–Њ–і –њ–Њ–Ј–≤–Њ–ї—П–µ—В –Є—Б–Ї–ї—О—З–Є—В—М —Б–Њ–њ—Г—В—Б—В–≤—Г—О—Й–Є–µ –њ–∞—В–Њ–ї–Њ–≥–Є–Є, –Ї–Њ—В–Њ—А—Л–µ –Љ–Њ–≥—Г—В –њ–Њ–і–і–µ—А–ґ–Є–≤–∞—В—М –≤–Њ—Б–њ–∞–ї–Є—В–µ–ї—М–љ—Л–є –њ—А–Њ—Ж–µ—Б—Б.
–Ґ–Њ—З–љ–∞—П –і–Є–∞–≥–љ–Њ—Б—В–Є–Ї–∞ вАФ –Њ—Б–љ–Њ–≤–∞ —Г—Б–њ–µ—И–љ–Њ–≥–Њ –ї–µ—З–µ–љ–Є—П –Є –њ—А–µ–і–Њ—В–≤—А–∞—Й–µ–љ–Є—П —А–µ—Ж–Є–і–Є–≤–Њ–≤ –±–Њ–ї–µ–Ј–љ–Є.

–Р–љ—В–Є–±–∞–Ї—В–µ—А–Є–∞–ї—М–љ–∞—П —В–µ—А–∞–њ–Є—П
–У–ї–∞–≤–љ–∞—П —Ж–µ–ї—М –ї–µ—З–µ–љ–Є—П вАФ —Г–љ–Є—З—В–Њ–ґ–µ–љ–Є–µ –≤–Њ–Ј–±—Г–і–Є—В–µ–ї—П –Є–љ—Д–µ–Ї—Ж–Є–Є. –Ф–ї—П —Н—В–Њ–≥–Њ –љ–∞–Ј–љ–∞—З–∞—О—В—Б—П –∞–љ—В–Є–±–Є–Њ—В–Є–Ї–Є —И–Є—А–Њ–Ї–Њ–≥–Њ –Є–ї–Є –љ–∞–њ—А–∞–≤–ї–µ–љ–љ–Њ–≥–Њ —Б–њ–µ–Ї—В—А–∞ –і–µ–є—Б—В–≤–Є—П –≤ –Ј–∞–≤–Є—Б–Є–Љ–Њ—Б—В–Є –Њ—В —А–µ–Ј—Г–ї—М—В–∞—В–Њ–≤ –±–∞–Ї—В–µ—А–Є–Њ–ї–Њ–≥–Є—З–µ—Б–Ї–Њ–≥–Њ –∞–љ–∞–ї–Є–Ј–∞. –Т–∞–ґ–љ–Њ —Б—В—А–Њ–≥–Њ —Б–Њ–±–ї—О–і–∞—В—М —Б—Е–µ–Љ—Г –њ—А–Є—С–Љ–∞, —З—В–Њ–±—Л –њ—А–µ–і–Њ—В–≤—А–∞—В–Є—В—М —А–∞–Ј–≤–Є—В–Є–µ —Г—Б—В–Њ–є—З–Є–≤–Њ—Б—В–Є –Љ–Є–Ї—А–Њ–Њ—А–≥–∞–љ–Є–Ј–Љ–Њ–≤.
–Э–∞–Ј–љ–∞—З–∞–µ–Љ—Л–µ –њ—А–µ–њ–∞—А–∞—В—Л –њ–Њ–і–±–Є—А–∞—О—В—Б—П –Є–љ–і–Є–≤–Є–і—Г–∞–ї—М–љ–Њ:
- —Д—В–Њ—А—Е–Є–љ–Њ–ї–Њ–љ—Л (—Ж–Є–њ—А–Њ—Д–ї–Њ–Ї—Б–∞—Ж–Є–љ, –Њ—Д–ї–Њ–Ї—Б–∞—Ж–Є–љ);
- –љ–Є—В—А–Њ—Д—Г—А–∞–љ—Л (—Д—Г—А–∞–і–Њ–љ–Є–љ, —Д—Г—А–∞–≥–Є–љ);
- —Ж–µ—Д–∞–ї–Њ—Б–њ–Њ—А–Є–љ—Л –Є–ї–Є –Љ–∞–Ї—А–Њ–ї–Є–і—Л –њ—А–Є –љ–µ–њ–µ—А–µ–љ–Њ—Б–Є–Љ–Њ—Б—В–Є –і—А—Г–≥–Є—Е –≥—А—Г–њ–њ.
–Ъ—Г—А—Б —В–µ—А–∞–њ–Є–Є –і–ї–Є—В—Б—П –Њ—В 7 –і–Њ 14 –і–љ–µ–є, –≤ –Ј–∞–≤–Є—Б–Є–Љ–Њ—Б—В–Є –Њ—В —В—П–ґ–µ—Б—В–Є –Ј–∞–±–Њ–ї–µ–≤–∞–љ–Є—П. –°–∞–Љ–Њ–≤–Њ–ї—М–љ–Њ–µ –њ—А–µ–Ї—А–∞—Й–µ–љ–Є–µ –њ—А–Є—С–Љ–∞ –∞–љ—В–Є–±–Є–Њ—В–Є–Ї–Њ–≤ –љ–µ–і–Њ–њ—Г—Б—В–Є–Љ–Њ, —В–∞–Ї –Ї–∞–Ї —Н—В–Њ –Љ–Њ–ґ–µ—В –њ—А–Є–≤–µ—Б—В–Є –Ї —А–µ—Ж–Є–і–Є–≤—Г –Є –њ–µ—А–µ—Е–Њ–і—Г –±–Њ–ї–µ–Ј–љ–Є –≤ —Е—А–Њ–љ–Є—З–µ—Б–Ї—Г—О —Д–Њ—А–Љ—Г.
–Я–Њ—Б–ї–µ –Њ–Ї–Њ–љ—З–∞–љ–Є—П –Ї—Г—А—Б–∞ —А–µ–Ї–Њ–Љ–µ–љ–і—Г–µ—В—Б—П –Ї–Њ–љ—В—А–Њ–ї—М–љ—Л–є –∞–љ–∞–ї–Є–Ј –Љ–Њ—З–Є –і–ї—П –Њ—Ж–µ–љ–Ї–Є —Н—Д—Д–µ–Ї—В–Є–≤–љ–Њ—Б—В–Є –ї–µ—З–µ–љ–Є—П.
–Я—А–Њ—В–Є–≤–Њ–≤–Њ—Б–њ–∞–ї–Є—В–µ–ї—М–љ—Л–µ –Є —Б–њ–∞–Ј–Љ–Њ–ї–Є—В–Є—З–µ—Б–Ї–Є–µ –њ—А–µ–њ–∞—А–∞—В—Л
–Ф–ї—П —Б–љ–Є–ґ–µ–љ–Є—П –≤–Њ—Б–њ–∞–ї–µ–љ–Є—П –њ—А–Є–Љ–µ–љ—П—О—В—Б—П –љ–µ—Б—В–µ—А–Њ–Є–і–љ—Л–µ –њ—А–Њ—В–Є–≤–Њ–≤–Њ—Б–њ–∞–ї–Є—В–µ–ї—М–љ—Л–µ —Б—А–µ–і—Б—В–≤–∞. –Ю–љ–Є —Г–Љ–µ–љ—М—И–∞—О—В –±–Њ–ї—М, —Г—Б—В—А–∞–љ—П—О—В –Њ—В—С–Ї —Б–ї–Є–Ј–Є—Б—В–Њ–є –Є –Њ–±–ї–µ–≥—З–∞—О—В –њ—А–Њ—Ж–µ—Б—Б –Љ–Њ—З–µ–Є—Б–њ—Г—Б–Ї–∞–љ–Є—П. –І–∞—Б—В–Њ –≤—А–∞—З –љ–∞–Ј–љ–∞—З–∞–µ—В –њ—А–µ–њ–∞—А–∞—В—Л –љ–∞ –Њ—Б–љ–Њ–≤–µ –Є–±—Г–њ—А–Њ—Д–µ–љ–∞ –Є–ї–Є –і–Є–Ї–ї–Њ—Д–µ–љ–∞–Ї–∞ –≤ —В–∞–±–ї–µ—В–Ї–∞—Е –Є–ї–Є —Б–≤–µ—З–∞—Е.
–І—В–Њ–±—Л —Б–љ—П—В—М —Б–њ–∞–Ј–Љ—Л –Љ–Њ—З–µ–≤–Њ–≥–Њ –њ—Г–Ј—Л—А—П –Є —Г—А–µ—В—А—Л, –Є—Б–њ–Њ–ї—М–Ј—Г—О—В—Б—П —Б–њ–∞–Ј–Љ–Њ–ї–Є—В–Є–Ї–Є, —В–∞–Ї–Є–µ –Ї–∞–Ї –і—А–Њ—В–∞–≤–µ—А–Є–љ –Є–ї–Є –њ–∞–њ–∞–≤–µ—А–Є–љ. –≠—В–Њ –њ–Њ–Љ–Њ–≥–∞–µ—В —Б–љ–Є–Ј–Є—В—М –±–Њ–ї–µ–Ј–љ–µ–љ–љ–Њ—Б—В—М –Є —З–∞—Б—В–Њ—В—Г –њ–Њ–Ј—Л–≤–Њ–≤ –Ї –Љ–Њ—З–µ–Є—Б–њ—Г—Б–Ї–∞–љ–Є—О. –Ф–Њ–њ–Њ–ї–љ–Є—В–µ–ї—М–љ–Њ –Љ–Њ–≥—Г—В –њ—А–Є–Љ–µ–љ—П—В—М—Б—П –Љ–µ—Б—В–љ—Л–µ –∞–љ—В–Є—Б–µ–њ—В–Є—З–µ—Б–Ї–Є–µ —А–∞—Б—В–≤–Њ—А—Л –і–ї—П –њ—А–Њ–Љ—Л–≤–∞–љ–Є–є —Г—А–µ—В—А—Л.
–Я—А–Є –Њ—Б—В—А–Њ–є —Д–Њ—А–Љ–µ –±–Њ–ї–µ–Ј–љ–Є –≤–∞–ґ–љ–Њ –Њ–±–µ—Б–њ–µ—З–Є—В—М –њ–Њ–Ї–Њ–є, –і–Њ—Б—В–∞—В–Њ—З–љ–Њ–µ –њ–Є—В—М—С –Є —Й–∞–і—П—Й—Г—О –і–Є–µ—В—Г, –Є—Б–Ї–ї—О—З–∞—О—Й—Г—О —А–∞–Ј–і—А–∞–ґ–∞—О—Й–Є–µ –њ—А–Њ–і—Г–Ї—В—Л. –Т—Б–µ –љ–∞–Ј–љ–∞—З–µ–љ–Є—П –і–µ–ї–∞—О—В—Б—П –њ–Њ–і –Ї–Њ–љ—В—А–Њ–ї–µ–Љ —Б–њ–µ—Ж–Є–∞–ї–Є—Б—В–∞, —З—В–Њ–±—Л –Є–Ј–±–µ–ґ–∞—В—М –Њ—Б–ї–Њ–ґ–љ–µ–љ–Є–є –Є –љ–µ–ґ–µ–ї–∞—В–µ–ї—М–љ—Л—Е —А–µ–∞–Ї—Ж–Є–є.
–°–Њ—З–µ—В–∞–љ–Є–µ —Б–Є—Б—В–µ–Љ–љ–Њ–є –Є –Љ–µ—Б—В–љ–Њ–є —В–µ—А–∞–њ–Є–Є —Г—Б–Ї–Њ—А—П–µ—В –≤–Њ—Б—Б—В–∞–љ–Њ–≤–ї–µ–љ–Є–µ —Б–ї–Є–Ј–Є—Б—В–Њ–є –Њ–±–Њ–ї–Њ—З–Ї–Є –Є –њ—А–µ–і–Њ—В–≤—А–∞—Й–∞–µ—В —Е—А–Њ–љ–Є–Ј–∞—Ж–Є—О –≤–Њ—Б–њ–∞–ї–µ–љ–Є—П.

–§–Є–Ј–Є–Њ—В–µ—А–∞–њ–µ–≤—В–Є—З–µ—Б–Ї–Є–µ –Љ–µ—В–Њ–і—Л –ї–µ—З–µ–љ–Є—П
–§–Є–Ј–Є–Њ—В–µ—А–∞–њ–Є—П –Є–≥—А–∞–µ—В –≤–∞–ґ–љ—Г—О —А–Њ–ї—М –≤ –Ї–Њ–Љ–њ–ї–µ–Ї—Б–љ–Њ–Љ –ї–µ—З–µ–љ–Є–Є —Г—А–µ—В—А–Њ—Ж–Є—Б—В–Є—В–∞. –Ю–љ–∞ –њ–Њ–Љ–Њ–≥–∞–µ—В —Г—Б–Є–ї–Є—В—М —Н—Д—Д–µ–Ї—В –Љ–µ–і–Є–Ї–∞–Љ–µ–љ—В–Њ–≤, —Г–ї—Г—З—И–∞–µ—В –Ї—А–Њ–≤–Њ—Б–љ–∞–±–ґ–µ–љ–Є–µ —В–Ї–∞–љ–µ–є –Є —Г—Б–Ї–Њ—А—П–µ—В –њ—А–Њ—Ж–µ—Б—Б –≤–Њ—Б—Б—В–∞–љ–Њ–≤–ї–µ–љ–Є—П. –Я—А–Њ—Ж–µ–і—Г—А—Л –љ–∞–Ј–љ–∞—З–∞—О—В—Б—П –њ–Њ—Б–ї–µ —Б—В–Є—Е–∞–љ–Є—П –Њ—Б—В—А–Њ–≥–Њ –≤–Њ—Б–њ–∞–ї–µ–љ–Є—П, –Ї–Њ–≥–і–∞ —В–µ–Љ–њ–µ—А–∞—В—Г—А–∞ —В–µ–ї–∞ –љ–Њ—А–Љ–∞–ї–Є–Ј—Г–µ—В—Б—П.
–Ш—Б–њ–Њ–ї—М–Ј—Г—О—В—Б—П –Љ–µ—В–Њ–і—Л:
- —Н–ї–µ–Ї—В—А–Њ—Д–Њ—А–µ–Ј —Б –њ—А–Њ—В–Є–≤–Њ–≤–Њ—Б–њ–∞–ї–Є—В–µ–ї—М–љ—Л–Љ–Є –њ—А–µ–њ–∞—А–∞—В–∞–Љ–Є;
- –Љ–∞–≥–љ–Є—В–Њ—В–µ—А–∞–њ–Є—П;
- –£–Т–І-—В–µ—А–∞–њ–Є—П;
- –ї–∞–Ј–µ—А–љ–Њ–µ –≤–Њ–Ј–і–µ–є—Б—В–≤–Є–µ.
–§–Є–Ј–Є–Њ—В–µ—А–∞–њ–Є—П —Б–њ–Њ—Б–Њ–±—Б—В–≤—Г–µ—В —Г–Љ–µ–љ—М—И–µ–љ–Є—О –±–Њ–ї–Є, —Г—Б–Ї–Њ—А—П–µ—В –Ј–∞–ґ–Є–≤–ї–µ–љ–Є–µ —Б–ї–Є–Ј–Є—Б—В–Њ–є –Є —Б–љ–Є–ґ–∞–µ—В —А–Є—Б–Ї —А–µ—Ж–Є–і–Є–≤–∞. –Ю–і–љ–∞–Ї–Њ –љ–∞–Ј–љ–∞—З–∞–µ—В—Б—П –Њ–љ–∞ —Б—В—А–Њ–≥–Њ –Є–љ–і–Є–≤–Є–і—Г–∞–ї—М–љ–Њ, –њ–Њ—Б–ї–µ –Њ—Ж–µ–љ–Ї–Є –Њ–±—Й–µ–≥–Њ —Б–Њ—Б—В–Њ—П–љ–Є—П –њ–∞—Ж–Є–µ–љ—В–∞.
–†–µ–≥—Г–ї—П—А–љ–Њ–µ –њ—А–Њ—Е–Њ–ґ–і–µ–љ–Є–µ –њ—А–Њ—Ж–µ–і—Г—А –њ–Њ–і –Ї–Њ–љ—В—А–Њ–ї–µ–Љ –≤—А–∞—З–∞ –њ–Њ–Љ–Њ–≥–∞–µ—В –і–Њ—Б—В–Є—З—М —Б—В–Њ–є–Ї–Њ–є —А–µ–Љ–Є—Б—Б–Є–Є –Є –њ—А–µ–і–Њ—В–≤—А–∞—В–Є—В—М –њ–Њ–≤—В–Њ—А–љ—Л–µ –≤–Њ—Б–њ–∞–ї–µ–љ–Є—П.
–Ф–Є–µ—В–Њ—В–µ—А–∞–њ–Є—П –њ—А–Є —Г—А–µ—В—А–Њ—Ж–Є—Б—В–Є—В–µ
–Я–Є—В–∞–љ–Є–µ –Є–≥—А–∞–µ—В –Ј–љ–∞—З–Є–Љ—Г—О —А–Њ–ї—М –≤ –њ—А–Њ—Ж–µ—Б—Б–µ –≤—Л–Ј–і–Њ—А–Њ–≤–ї–µ–љ–Є—П. –¶–µ–ї—М –і–Є–µ—В—Л вАФ —Г–Љ–µ–љ—М—И–Є—В—М —А–∞–Ј–і—А–∞–ґ–µ–љ–Є–µ –Љ–Њ—З–µ–≤–Њ–≥–Њ –њ—Г–Ј—Л—А—П, —Б–љ–Є–Ј–Є—В—М –љ–∞–≥—А—Г–Ј–Ї—Г –љ–∞ –њ–Њ—З–Ї–Є –Є –Њ–±–µ—Б–њ–µ—З–Є—В—М –Њ—А–≥–∞–љ–Є–Ј–Љ –љ–µ–Њ–±—Е–Њ–і–Є–Љ—Л–Љ–Є –≤–µ—Й–µ—Б—В–≤–∞–Љ–Є. –Ш–Ј —А–∞—Ж–Є–Њ–љ–∞ –Є—Б–Ї–ї—О—З–∞—О—В—Б—П –Њ—Б—В—А—Л–µ, –Ї–Є—Б–ї—Л–µ, –ґ–∞—А–µ–љ—Л–µ –±–ї—О–і–∞ –Є –∞–ї–Ї–Њ–≥–Њ–ї—М.
–†–µ–Ї–Њ–Љ–µ–љ–і—Г—О—В—Б—П –њ—А–Њ–і—Г–Ї—В—Л:
- –Њ–≤–Њ—Й–Є, –±–Њ–≥–∞—В—Л–µ –Ї–ї–µ—В—З–∞—В–Ї–Њ–є;
- –Ї–∞—И–Є –Є –Њ—В–≤–∞—А–љ–Њ–µ –Љ—П—Б–Њ;
- –Љ–Њ–ї–Њ—З–љ–Њ–Ї–Є—Б–ї—Л–µ –њ—А–Њ–і—Г–Ї—В—Л;
- –і–Њ—Б—В–∞—В–Њ—З–љ–Њ–µ –Ї–Њ–ї–Є—З–µ—Б—В–≤–Њ —З–Є—Б—В–Њ–є –≤–Њ–і—Л.
–°–ї–µ–і—Г–µ—В –Є–Ј–±–µ–≥–∞—В—М –Ї–Њ—Д–µ, –Ї—А–µ–њ–Ї–Њ–≥–Њ —З–∞—П –Є –≥–∞–Ј–Є—А–Њ–≤–∞–љ–љ—Л—Е –љ–∞–њ–Є—В–Ї–Њ–≤, –Ї–Њ—В–Њ—А—Л–µ —А–∞–Ј–і—А–∞–ґ–∞—О—В —Б–ї–Є–Ј–Є—Б—В—Г—О. –£–њ–Њ—А –і–µ–ї–∞–µ—В—Б—П –љ–∞ —В—С–њ–ї—Г—О, –Љ—П–≥–Ї—Г—О –Є –љ–µ–є—В—А–∞–ї—М–љ—Г—О –њ–Є—Й—Г. –°–Њ–±–ї—О–і–µ–љ–Є–µ –і–Є–µ—В—Л –њ–Њ–Љ–Њ–≥–∞–µ—В —Г—Б–Ї–Њ—А–Є—В—М –≤–Њ—Б—Б—В–∞–љ–Њ–≤–ї–µ–љ–Є–µ –Є –њ–Њ–≤—Л—Б–Є—В—М —Н—Д—Д–µ–Ї—В–Є–≤–љ–Њ—Б—В—М –Љ–µ–і–Є–Ї–∞–Љ–µ–љ—В–Њ–Ј–љ–Њ–є —В–µ—А–∞–њ–Є–Є.
–†–µ–≥—Г–ї—П—А–љ–Њ–µ –њ–Є—В—М—С –Њ—З–Є—Й–∞–µ—В –Љ–Њ—З–µ–≤—Л–≤–Њ–і—П—Й–Є–µ –њ—Г—В–Є –Є —Б–њ–Њ—Б–Њ–±—Б—В–≤—Г–µ—В –≤—Л–≤–µ–і–µ–љ–Є—О –±–∞–Ї—В–µ—А–Є–є –Є–Ј –Њ—А–≥–∞–љ–Є–Ј–Љ–∞.

–Ь–µ—Б—В–љ–Њ–µ –ї–µ—З–µ–љ–Є–µ –Є –Є–љ—Б—В–Є–ї–ї—П—Ж–Є–Є
–Т –љ–µ–Ї–Њ—В–Њ—А—Л—Е —Б–ї—Г—З–∞—П—Е —Н—Д—Д–µ–Ї—В–Є–≤–љ—Л–Љ –Љ–µ—В–Њ–і–Њ–Љ —П–≤–ї—П–µ—В—Б—П –Љ–µ—Б—В–љ–Њ–µ –≤–≤–µ–і–µ–љ–Є–µ –ї–µ–Ї–∞—А—Б—В–≤–µ–љ–љ—Л—Е —А–∞—Б—В–≤–Њ—А–Њ–≤ –≤ —Г—А–µ—В—А—Г –Є–ї–Є –Љ–Њ—З–µ–≤–Њ–є –њ—Г–Ј—Л—А—М. –Ш–љ—Б—В–Є–ї–ї—П—Ж–Є–Є –њ–Њ–Ј–≤–Њ–ї—П—О—В –і–Њ—Б—В–∞–≤–Є—В—М –њ—А–µ–њ–∞—А–∞—В—Л –љ–∞–њ—А—П–Љ—Г—О –Ї –Њ—З–∞–≥—Г –≤–Њ—Б–њ–∞–ї–µ–љ–Є—П, —З—В–Њ —Г—Б–Є–ї–Є–≤–∞–µ—В –Є—Е –і–µ–є—Б—В–≤–Є–µ. –Я—А–Њ—Ж–µ–і—Г—А–∞ –њ—А–Њ–≤–Њ–і–Є—В—Б—П –≤ —Г—Б–ї–Њ–≤–Є—П—Е –Ї–ї–Є–љ–Є–Ї–Є —Б —Б–Њ–±–ї—О–і–µ–љ–Є–µ–Љ —Б—В–µ—А–Є–ї—М–љ–Њ—Б—В–Є.
–Ф–ї—П –Є–љ—Б—В–Є–ї–ї—П—Ж–Є–є –Є—Б–њ–Њ–ї—М–Ј—Г—О—В—Б—П:
- –∞–љ—В–Є—Б–µ–њ—В–Є—З–µ—Б–Ї–Є–µ —А–∞—Б—В–≤–Њ—А—Л;
- –∞–љ—В–Є–±–Є–Њ—В–Є–Ї–Є;
- —Б—А–µ–і—Б—В–≤–∞, –≤–Њ—Б—Б—В–∞–љ–∞–≤–ї–Є–≤–∞—О—Й–Є–µ —Б–ї–Є–Ј–Є—Б—В—Г—О –Њ–±–Њ–ї–Њ—З–Ї—Г.
–Ґ–∞–Ї–∞—П —В–µ—А–∞–њ–Є—П –Њ—Б–Њ–±–µ–љ–љ–Њ –њ–Њ–ї–µ–Ј–љ–∞ –њ—А–Є —Е—А–Њ–љ–Є—З–µ—Б–Ї–Є—Е —Д–Њ—А–Љ–∞—Е –Ј–∞–±–Њ–ї–µ–≤–∞–љ–Є—П, –Ї–Њ–≥–і–∞ —В—А–µ–±—Г–µ—В—Б—П –≥–ї—Г–±–Њ–Ї–Њ–µ –≤–Њ–Ј–і–µ–є—Б—В–≤–Є–µ –љ–∞ –њ–Њ—А–∞–ґ—С–љ–љ—Л–µ —В–Ї–∞–љ–Є. –Ю–љ–∞ —Б–Њ—З–µ—В–∞–µ—В—Б—П —Б —Б–Є—Б—В–µ–Љ–љ—Л–Љ–Є –њ—А–µ–њ–∞—А–∞—В–∞–Љ–Є –Є —Д–Є–Ј–Є–Њ—В–µ—А–∞–њ–Є–µ–є, –Њ–±–µ—Б–њ–µ—З–Є–≤–∞—П –Ї–Њ–Љ–њ–ї–µ–Ї—Б–љ—Л–є —А–µ–Ј—Г–ї—М—В–∞—В.
–†–µ–≥—Г–ї—П—А–љ—Л–µ –Є–љ—Б—В–Є–ї–ї—П—Ж–Є–Є –њ–Њ–Ј–≤–Њ–ї—П—О—В —Г–Љ–µ–љ—М—И–Є—В—М –≤–Њ—Б–њ–∞–ї–µ–љ–Є–µ –Є –њ—А–µ–і–Њ—В–≤—А–∞—В–Є—В—М –њ–Њ–≤—В–Њ—А–љ–Њ–µ –Ј–∞—А–∞–ґ–µ–љ–Є–µ.
–Ы–µ—З–µ–љ–Є–µ —Е—А–Њ–љ–Є—З–µ—Б–Ї–Њ–≥–Њ —Г—А–µ—В—А–Њ—Ж–Є—Б—В–Є—В–∞
–•—А–Њ–љ–Є—З–µ—Б–Ї–∞—П —Д–Њ—А–Љ–∞ —В—А–µ–±—Г–µ—В –±–Њ–ї–µ–µ –і–ї–Є—В–µ–ї—М–љ–Њ–є –Є —Б–Є—Б—В–µ–Љ–љ–Њ–є —В–µ—А–∞–њ–Є–Є. –Т—А–∞—З –њ–Њ–і–±–Є—А–∞–µ—В –Є–љ–і–Є–≤–Є–і—Г–∞–ї—М–љ—Г—О —Б—Е–µ–Љ—Г —Б —Г—З—С—В–Њ–Љ —З–∞—Б—В–Њ—В—Л —А–µ—Ж–Є–і–Є–≤–Њ–≤, —Б–Њ—Б—В–Њ—П–љ–Є—П –Є–Љ–Љ—Г–љ–љ–Њ–є —Б–Є—Б—В–µ–Љ—Л –Є —З—Г–≤—Б—В–≤–Є—В–µ–ї—М–љ–Њ—Б—В–Є –±–∞–Ї—В–µ—А–Є–є. –Я—А–Є –љ–µ–Њ–±—Е–Њ–і–Є–Љ–Њ—Б—В–Є –њ—А–Є–Љ–µ–љ—П—О—В—Б—П –Ї—Г—А—Б—Л –Є–Љ–Љ—Г–љ–Њ–Љ–Њ–і—Г–ї–Є—А—Г—О—Й–Є—Е –њ—А–µ–њ–∞—А–∞—В–Њ–≤.
–Я—А–Њ–≤–Њ–і–Є—В—Б—П —Г—Б—В—А–∞–љ–µ–љ–Є–µ –≤—Б–µ—Е –≤–Њ–Ј–Љ–Њ–ґ–љ—Л—Е –Њ—З–∞–≥–Њ–≤ –Є–љ—Д–µ–Ї—Ж–Є–Є:
- –ї–µ—З–µ–љ–Є–µ –њ–Њ–ї–Њ–≤—Л—Е –Є–љ—Д–µ–Ї—Ж–Є–є;
- —Б–∞–љ–∞—Ж–Є—П –њ–Њ–ї–Њ—Б—В–Є —А—В–∞ –Є –љ–Њ—Б–Њ–≥–ї–Њ—В–Ї–Є;
- –Ї–Њ—А—А–µ–Ї—Ж–Є—П –≥–Њ—А–Љ–Њ–љ–∞–ї—М–љ–Њ–≥–Њ —Д–Њ–љ–∞.
–Т–∞–ґ–љ–Њ –Є–Ј–±–µ–≥–∞—В—М –њ–µ—А–µ–Њ—Е–ї–∞–ґ–і–µ–љ–Є—П –Є —Б–Њ–±–ї—О–і–∞—В—М –њ—А–∞–≤–Є–ї–∞ –Є–љ—В–Є–Љ–љ–Њ–є –≥–Є–≥–Є–µ–љ—Л. –Ц–µ–љ—Й–Є–љ–∞–Љ —А–µ–Ї–Њ–Љ–µ–љ–і—Г–µ—В—Б—П –љ–Њ—Б–Є—В—М —Г–і–Њ–±–љ–Њ–µ –±–µ–ї—М—С –Є–Ј –љ–∞—В—Г—А–∞–ї—М–љ—Л—Е —В–Ї–∞–љ–µ–є, –∞ –Љ—Г–ґ—З–Є–љ–∞–Љ вАФ —Б–ї–µ–і–Є—В—М –Ј–∞ —Б–Њ—Б—В–Њ—П–љ–Є–µ–Љ –њ—А–µ–і—Б—В–∞—В–µ–ї—М–љ–Њ–є –ґ–µ–ї–µ–Ј—Л.
–†–µ–≥—Г–ї—П—А–љ–Њ–µ –љ–∞–±–ї—О–і–µ–љ–Є–µ —Г —Г—А–Њ–ї–Њ–≥–∞ –њ–Њ–Љ–Њ–≥–∞–µ—В –Ї–Њ–љ—В—А–Њ–ї–Є—А–Њ–≤–∞—В—М —В–µ—З–µ–љ–Є–µ –±–Њ–ї–µ–Ј–љ–Є –Є –њ—А–µ–і–Њ—В–≤—А–∞—Й–∞—В—М –Њ—Б–ї–Њ–ґ–љ–µ–љ–Є—П.

–Ш–Љ–Љ—Г–љ–Њ–Ї–Њ—А—А–µ–Ї—Ж–Є—П –Є –њ–Њ–і–і–µ—А–ґ–Є–≤–∞—О—Й–∞—П —В–µ—А–∞–њ–Є—П
–Ф–ї—П –њ—А–µ–і–Њ—В–≤—А–∞—Й–µ–љ–Є—П —А–µ—Ж–Є–і–Є–≤–Њ–≤ –љ–∞–Ј–љ–∞—З–∞—О—В—Б—П –њ—А–µ–њ–∞—А–∞—В—Л, –њ–Њ–≤—Л—И–∞—О—Й–Є–µ –Є–Љ–Љ—Г–љ–Є—В–µ—В. –≠—В–Њ –Љ–Њ–≥—Г—В –±—Л—В—М –≤–Є—В–∞–Љ–Є–љ—Л, —А–∞—Б—В–Є—В–µ–ї—М–љ—Л–µ –Є–Љ–Љ—Г–љ–Њ–Љ–Њ–і—Г–ї—П—В–Њ—А—Л –Є –±–Є–Њ—А–µ–≥—Г–ї—П—В–Њ—А—Л. –Ю–љ–Є –њ–Њ–Љ–Њ–≥–∞—О—В –Њ—А–≥–∞–љ–Є–Ј–Љ—Г –±–Њ—А–Њ—В—М—Б—П —Б –Є–љ—Д–µ–Ї—Ж–Є–µ–є –Є –≤–Њ—Б—Б—В–∞–љ–∞–≤–ї–Є–≤–∞—В—М—Б—П –њ–Њ—Б–ї–µ –Ї—Г—А—Б–∞ –∞–љ—В–Є–±–Є–Њ—В–Є–Ї–Њ–≤.
–Ґ–∞–Ї–ґ–µ –њ–Њ–ї–µ–Ј–љ–Њ –њ—А–Є–љ–Є–Љ–∞—В—М:
- –≤–Є—В–∞–Љ–Є–љ–љ—Л–µ –Ї–Њ–Љ–њ–ї–µ–Ї—Б—Л —Б —Ж–Є–љ–Ї–Њ–Љ –Є —Б–µ–ї–µ–љ–Њ–Љ;
- –њ—А–µ–њ–∞—А–∞—В—Л –љ–∞ –Њ—Б–љ–Њ–≤–µ —Н—Е–Є–љ–∞—Ж–µ–Є –Є–ї–Є –ґ–µ–љ—М—И–µ–љ—П;
- –њ—А–Њ–±–Є–Њ—В–Є–Ї–Є –і–ї—П –≤–Њ—Б—Б—В–∞–љ–Њ–≤–ї–µ–љ–Є—П –Љ–Є–Ї—А–Њ—Д–ї–Њ—А—Л.
–Я–Њ–і–і–µ—А–ґ–Є–≤–∞—О—Й–∞—П —В–µ—А–∞–њ–Є—П –≤–Ї–ї—О—З–∞–µ—В —А–µ–≥—Г–ї—П—А–љ—Л–µ –Ї—Г—А—Б—Л –Ї–Њ–љ—В—А–Њ–ї—П –Є –њ—А–Њ—Д–Є–ї–∞–Ї—В–Є–Ї–Є. –Т—А–∞—З –Љ–Њ–ґ–µ—В —А–µ–Ї–Њ–Љ–µ–љ–і–Њ–≤–∞—В—М –њ–Њ–≤—В–Њ—А–љ–Њ–µ –Њ–±—Б–ї–µ–і–Њ–≤–∞–љ–Є–µ —З–µ—А–µ–Ј –љ–µ—Б–Ї–Њ–ї—М–Ї–Њ –Љ–µ—Б—П—Ж–µ–≤ –њ–Њ—Б–ї–µ –≤—Л–Ј–і–Њ—А–Њ–≤–ї–µ–љ–Є—П.
–Ъ–Њ–Љ–њ–ї–µ–Ї—Б–љ—Л–є –њ–Њ–і—Е–Њ–і –њ–Њ–Љ–Њ–≥–∞–µ—В —Г–Ї—А–µ–њ–Є—В—М –Њ—А–≥–∞–љ–Є–Ј–Љ –Є —Б–љ–Є–Ј–Є—В—М —А–Є—Б–Ї –њ–Њ–≤—В–Њ—А–љ–Њ–≥–Њ –≤–Њ—Б–њ–∞–ї–µ–љ–Є—П.
–Ю—Б–Њ–±–µ–љ–љ–Њ—Б—В–Є –ї–µ—З–µ–љ–Є—П —Г –ґ–µ–љ—Й–Є–љ –Є –Љ—Г–ґ—З–Є–љ
–£ –ґ–µ–љ—Й–Є–љ —Г—А–µ—В—А–Њ—Ж–Є—Б—В–Є—В –≤—Б—В—А–µ—З–∞–µ—В—Б—П —З–∞—Й–µ –Є–Ј-–Ј–∞ –∞–љ–∞—В–Њ–Љ–Є—З–µ—Б–Ї–Є—Е –Њ—Б–Њ–±–µ–љ–љ–Њ—Б—В–µ–є –Љ–Њ—З–µ–њ–Њ–ї–Њ–≤–Њ–є —Б–Є—Б—В–µ–Љ—Л. –£–Ї–Њ—А–Њ—З–µ–љ–љ–∞—П —Г—А–µ—В—А–∞ —Б–њ–Њ—Б–Њ–±—Б—В–≤—Г–µ—В –±—Л—Б—В—А–Њ–Љ—Г –њ—А–Њ–љ–Є–Ї–љ–Њ–≤–µ–љ–Є—О –Є–љ—Д–µ–Ї—Ж–Є–Є. –Ы–µ—З–µ–љ–Є–µ –љ–∞–њ—А–∞–≤–ї–µ–љ–Њ –љ–µ —В–Њ–ї—М–Ї–Њ –љ–∞ —Г—Б—В—А–∞–љ–µ–љ–Є–µ —Б–Є–Љ–њ—В–Њ–Љ–Њ–≤, –љ–Њ –Є –љ–∞ –њ—А–Њ—Д–Є–ї–∞–Ї—В–Є–Ї—Г –≤–∞–≥–Є–љ–∞–ї—М–љ—Л—Е –Є–љ—Д–µ–Ї—Ж–Є–є.
–£ –Љ—Г–ґ—З–Є–љ –Ј–∞–±–Њ–ї–µ–≤–∞–љ–Є–µ –Љ–Њ–ґ–µ—В —Б–Њ—З–µ—В–∞—В—М—Б—П —Б –≤–Њ—Б–њ–∞–ї–µ–љ–Є–µ–Љ –њ—А–Њ—Б—В–∞—В—Л –Є–ї–Є —Б–µ–Љ–µ–љ–љ—Л—Е –њ—Г–Ј—Л—А—М–Ї–Њ–≤, —З—В–Њ —В—А–µ–±—Г–µ—В –±–Њ–ї–µ–µ –і–ї–Є—В–µ–ї—М–љ–Њ–≥–Њ –ї–µ—З–µ–љ–Є—П. –Я—А–Є —Н—В–Њ–Љ –≤–∞–ґ–љ–Њ –њ—А–Њ–≤–Њ–і–Є—В—М –Њ–±—Б–ї–µ–і–Њ–≤–∞–љ–Є–µ –њ–∞—А—В–љ—С—А–∞ –і–ї—П –Є—Б–Ї–ї—О—З–µ–љ–Є—П –њ–Њ–≤—В–Њ—А–љ–Њ–≥–Њ –Ј–∞—А–∞–ґ–µ–љ–Є—П.
–°–≤–Њ–µ–≤—А–µ–Љ–µ–љ–љ–Њ–µ –Њ–±—А–∞—Й–µ–љ–Є–µ –Ї –≤—А–∞—З—Г –њ–Њ–Љ–Њ–≥–∞–µ—В –Є–Ј–±–µ–ґ–∞—В—М –Њ—Б–ї–Њ–ґ–љ–µ–љ–Є–є, —В–∞–Ї–Є—Е –Ї–∞–Ї —Е—А–Њ–љ–Є—З–µ—Б–Ї–Є–µ –±–Њ–ї–Є –Є –љ–∞—А—Г—И–µ–љ–Є–µ —Д—Г–љ–Ї—Ж–Є–Є –Љ–Њ—З–µ–≤–Њ–≥–Њ –њ—Г–Ј—Л—А—П.
–Ш–љ–і–Є–≤–Є–і—Г–∞–ї—М–љ—Л–є –њ–Њ–і—Е–Њ–і –Ї —В–µ—А–∞–њ–Є–Є –њ–Њ–Ј–≤–Њ–ї—П–µ—В –і–Њ—Б—В–Є—З—М –њ–Њ–ї–љ–Њ–≥–Њ –≤—Л–Ј–і–Њ—А–Њ–≤–ї–µ–љ–Є—П –Є –њ—А–µ–і–Њ—В–≤—А–∞—В–Є—В—М —А–µ—Ж–Є–і–Є–≤.

–Я—А–Њ—Д–Є–ї–∞–Ї—В–Є–Ї–∞ —Г—А–µ—В—А–Њ—Ж–Є—Б—В–Є—В–∞
–Ю—Б–љ–Њ–≤–Њ–є –њ—А–Њ—Д–Є–ї–∞–Ї—В–Є–Ї–Є —П–≤–ї—П–µ—В—Б—П —Б–Њ–±–ї—О–і–µ–љ–Є–µ –≥–Є–≥–Є–µ–љ—Л –Є —Г–Ї—А–µ–њ–ї–µ–љ–Є–µ –Є–Љ–Љ—Г–љ–Є—В–µ—В–∞. –Э–µ–Њ–±—Е–Њ–і–Є–Љ–Њ –Є–Ј–±–µ–≥–∞—В—М –њ–µ—А–µ–Њ—Е–ї–∞–ґ–і–µ–љ–Є—П, –Њ—Б–Њ–±–µ–љ–љ–Њ –≤ –Њ–±–ї–∞—Б—В–Є —В–∞–Ј–∞, –Є —Б–≤–Њ–µ–≤—А–µ–Љ–µ–љ–љ–Њ –ї–µ—З–Є—В—М –Є–љ—Д–µ–Ї—Ж–Є–Є –Љ–Њ—З–µ–њ–Њ–ї–Њ–≤—Л—Е –њ—Г—В–µ–є. –Т–∞–ґ–љ–Њ –њ–Є—В—М –і–Њ—Б—В–∞—В–Њ—З–љ–Њ–µ –Ї–Њ–ї–Є—З–µ—Б—В–≤–Њ –ґ–Є–і–Ї–Њ—Б—В–Є –Є –љ–µ –Ј–∞–і–µ—А–ґ–Є–≤–∞—В—М –Љ–Њ—З–µ–Є—Б–њ—Г—Б–Ї–∞–љ–Є–µ.
–†–µ–Ї–Њ–Љ–µ–љ–і—Г–µ—В—Б—П:
- –љ–Њ—Б–Є—В—М –љ–∞—В—Г—А–∞–ї—М–љ–Њ–µ –±–µ–ї—М—С;
- –Є–Ј–±–µ–≥–∞—В—М —В–µ—Б–љ–Њ–є –Њ–і–µ–ґ–і—Л;
- —Б–Њ–±–ї—О–і–∞—В—М —А–µ–ґ–Є–Љ —В—А—Г–і–∞ –Є –Њ—В–і—Л—Е–∞;
- –Њ–≥—А–∞–љ–Є—З–Є—В—М —Г–њ–Њ—В—А–µ–±–ї–µ–љ–Є–µ —А–∞–Ј–і—А–∞–ґ–∞—О—Й–Є—Е –љ–∞–њ–Є—В–Ї–Њ–≤.
–Ґ–∞–Ї–ґ–µ –њ–Њ–ї–µ–Ј–љ–Њ —А–µ–≥—Г–ї—П—А–љ–Њ –њ—А–Њ—Е–Њ–і–Є—В—М –њ—А–Њ—Д–Є–ї–∞–Ї—В–Є—З–µ—Б–Ї–Є–µ –Њ—Б–Љ–Њ—В—А—Л —Г —Г—А–Њ–ї–Њ–≥–∞, –Њ—Б–Њ–±–µ–љ–љ–Њ –њ—А–Є —Б–Ї–ї–Њ–љ–љ–Њ—Б—В–Є –Ї –≤–Њ—Б–њ–∞–ї–Є—В–µ–ї—М–љ—Л–Љ –Ј–∞–±–Њ–ї–µ–≤–∞–љ–Є—П–Љ. –≠—В–Њ –њ–Њ–Ј–≤–Њ–ї—П–µ—В –≤—Л—П–≤–Є—В—М –љ–∞—А—Г—И–µ–љ–Є—П –љ–∞ —А–∞–љ–љ–µ–є —Б—В–∞–і–Є–Є.
–°–Њ–±–ї—О–і–µ–љ–Є–µ —Н—В–Є—Е –њ—А–Њ—Б—В—Л—Е –њ—А–∞–≤–Є–ї –Ј–љ–∞—З–Є—В–µ–ї—М–љ–Њ —Б–љ–Є–ґ–∞–µ—В —А–Є—Б–Ї —А–∞–Ј–≤–Є—В–Є—П –Ј–∞–±–Њ–ї–µ–≤–∞–љ–Є—П.
–Я–Њ—З–µ–Љ—Г –≤—Л–±–Є—А–∞—О—В –Ї–ї–Є–љ–Є–Ї—Г ¬Ђ–Ц–Є–Ј–љ—М-–Ю–њ–Њ—А–∞¬ї
–Ъ–ї–Є–љ–Є–Ї–∞ ¬Ђ–Ц–Є–Ј–љ—М-–Ю–њ–Њ—А–∞¬ї —Б–њ–µ—Ж–Є–∞–ї–Є–Ј–Є—А—Г–µ—В—Б—П –љ–∞ –і–Є–∞–≥–љ–Њ—Б—В–Є–Ї–µ –Є –ї–µ—З–µ–љ–Є–Є –Ј–∞–±–Њ–ї–µ–≤–∞–љ–Є–є –Љ–Њ—З–µ–њ–Њ–ї–Њ–≤–Њ–є —Б–Є—Б—В–µ–Љ—Л. –Ч–і–µ—Б—М —А–∞–±–Њ—В–∞—О—В –Њ–њ—Л—В–љ—Л–µ —Г—А–Њ–ї–Њ–≥–Є, –њ—А–Є–Љ–µ–љ—П—О—Й–Є–µ —Б–Њ–≤—А–µ–Љ–µ–љ–љ—Л–µ –Љ–µ—В–Њ–і—Л —В–µ—А–∞–њ–Є–Є –Є –Є–љ–і–Є–≤–Є–і—Г–∞–ї—М–љ—Л–є –њ–Њ–і—Е–Њ–і –Ї –Ї–∞–ґ–і–Њ–Љ—Г –њ–∞—Ж–Є–µ–љ—В—Г. –Т—Б–µ –њ—А–Њ—Ж–µ–і—Г—А—Л –њ—А–Њ–≤–Њ–і—П—В—Б—П –≤ –Ї–Њ–Љ—Д–Њ—А—В–љ—Л—Е —Г—Б–ї–Њ–≤–Є—П—Е —Б –Є—Б–њ–Њ–ї—М–Ј–Њ–≤–∞–љ–Є–µ–Љ —Б–µ—А—В–Є—Д–Є—Ж–Є—А–Њ–≤–∞–љ–љ—Л—Е –њ—А–µ–њ–∞—А–∞—В–Њ–≤.
–Я–∞—Ж–Є–µ–љ—В—Л –≤—Л–±–Є—А–∞—О—В —Н—В—Г –Ї–ї–Є–љ–Є–Ї—Г –Ј–∞ –≤—Л—Б–Њ–Ї–Њ–µ –Ї–∞—З–µ—Б—В–≤–Њ –Њ–±—Б–ї—Г–ґ–Є–≤–∞–љ–Є—П, —В–Њ—З–љ—Г—О –і–Є–∞–≥–љ–Њ—Б—В–Є–Ї—Г –Є –≤–љ–Є–Љ–∞—В–µ–ї—М–љ–Њ–µ –Њ—В–љ–Њ—И–µ–љ–Є–µ. –Ч–і–µ—Б—М –њ—А–Њ–≤–Њ–і—П—В –њ–Њ–ї–љ–Њ–µ –≤–Њ—Б—Б—В–∞–љ–Њ–≤–ї–µ–љ–Є–µ –њ–Њ—Б–ї–µ –≤–Њ—Б–њ–∞–ї–Є—В–µ–ї—М–љ—Л—Е –Ј–∞–±–Њ–ї–µ–≤–∞–љ–Є–є, –Ї–Њ–љ—В—А–Њ–ї–Є—А—Г—П —Б–Њ—Б—В–Њ—П–љ–Є–µ –і–Њ –њ–Њ–ї–љ–Њ–≥–Њ –≤—Л–Ј–і–Њ—А–Њ–≤–ї–µ–љ–Є—П.
–Ґ–∞–Ї–ґ–µ –і–Њ—Б—В—Г–њ–љ–∞ —Б–Њ–≤—А–µ–Љ–µ–љ–љ–∞—П –ї–∞–±–Њ—А–∞—В–Њ—А–љ–∞—П –±–∞–Ј–∞ –Є —Д–Є–Ј–Є–Њ—В–µ—А–∞–њ–µ–≤—В–Є—З–µ—Б–Ї–Њ–µ –Њ–±–Њ—А—Г–і–Њ–≤–∞–љ–Є–µ, –њ–Њ–Ј–≤–Њ–ї—П—О—Й–µ–µ —Н—Д—Д–µ–Ї—В–Є–≤–љ–Њ —Г—Б—В—А–∞–љ—П—В—М –і–∞–ґ–µ —Е—А–Њ–љ–Є—З–µ—Б–Ї–Є–µ —Д–Њ—А–Љ—Л –±–Њ–ї–µ–Ј–љ–Є.
–Ю–±—А–∞—Й–∞—П—Б—М –≤ –Ї–ї–Є–љ–Є–Ї—Г ¬Ђ–Ц–Є–Ј–љ—М-–Ю–њ–Њ—А–∞¬ї, –њ–∞—Ж–Є–µ–љ—В—Л –њ–Њ–ї—Г—З–∞—О—В –Ї–Њ–Љ–њ–ї–µ–Ї—Б–љ–Њ–µ –ї–µ—З–µ–љ–Є–µ, –њ—А–Њ—Д–µ—Б—Б–Є–Њ–љ–∞–ї—М–љ—Г—О –њ–Њ–і–і–µ—А–ґ–Ї—Г –Є –≥–∞—А–∞–љ—В–Є—А–Њ–≤–∞–љ–љ—Л–є —А–µ–Ј—Г–ї—М—В–∞—В.
–Я–Њ—З–µ–Љ—Г –≤—Л–±–Є—А–∞—О—В –љ–∞—Б?

–Т–Њ–њ—А–Њ—Б-–Њ—В–≤–µ—В
–°—В–∞—В—М–Є
–Ю—В–Ј—Л–≤—Л
–Я–µ—А—Б–Њ–љ–∞–ї—М–љ—Л–µ –њ—А–µ–і–ї–Њ–ґ–µ–љ–Є—П –і–ї—П –≤–∞—Б
–£—Б–ї—Г–≥–Є –љ–∞—И–µ–є –Ї–ї–Є–љ–Є–Ї–Є





–Ч–∞—П–≤–Ї–∞ –њ—А–Є–љ—П—В–∞
–Р–і—А–µ—Б –Ї–ї–Є–љ–Є–Ї–Є
–°–± вАУ –Т—Б —Б 9:00 –і–Њ 19:00
–°–± вАУ –Т—Б —Б 9:00 –і–Њ 19:00








 –≥. –Х–Ї–∞—В–µ—А–Є–љ–±—Г—А–≥ —Г–ї. –Ѓ–ї–Є—Г—Б–∞ –§—Г—З–Є–Ї–∞, 11
–≥. –Х–Ї–∞—В–µ—А–Є–љ–±—Г—А–≥ —Г–ї. –Ѓ–ї–Є—Г—Б–∞ –§—Г—З–Є–Ї–∞, 11